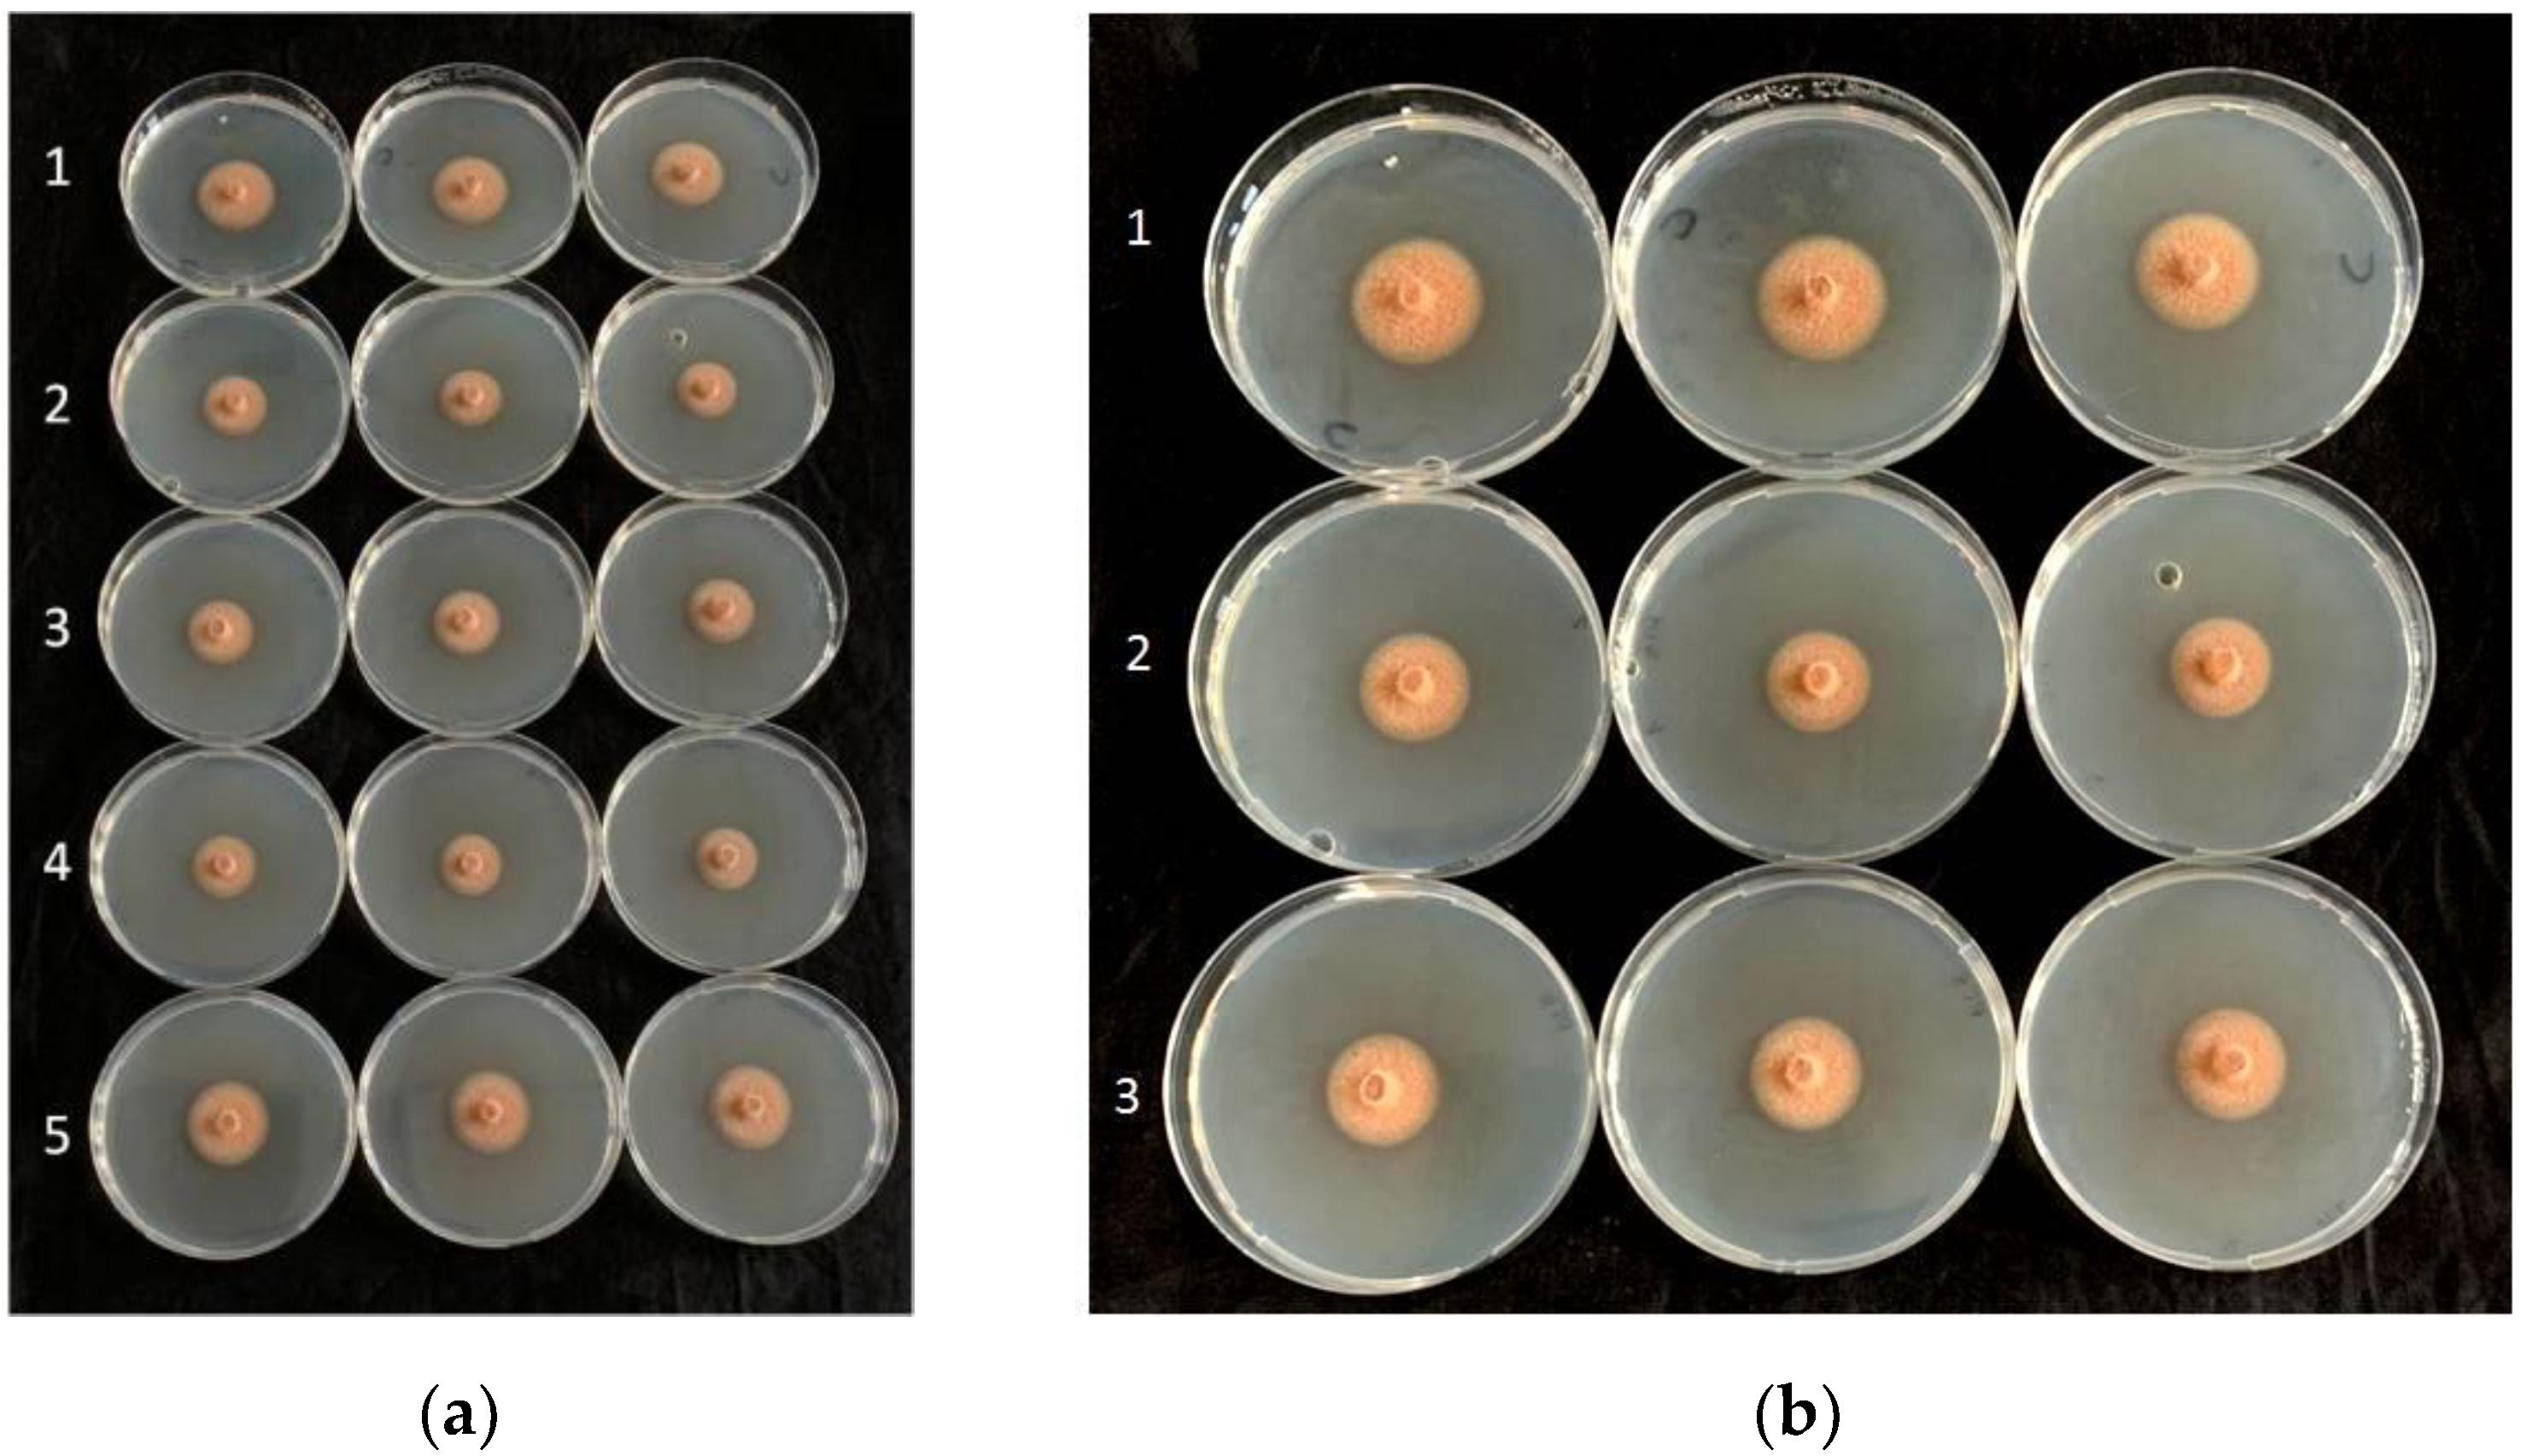
Plants 11 00446 g002
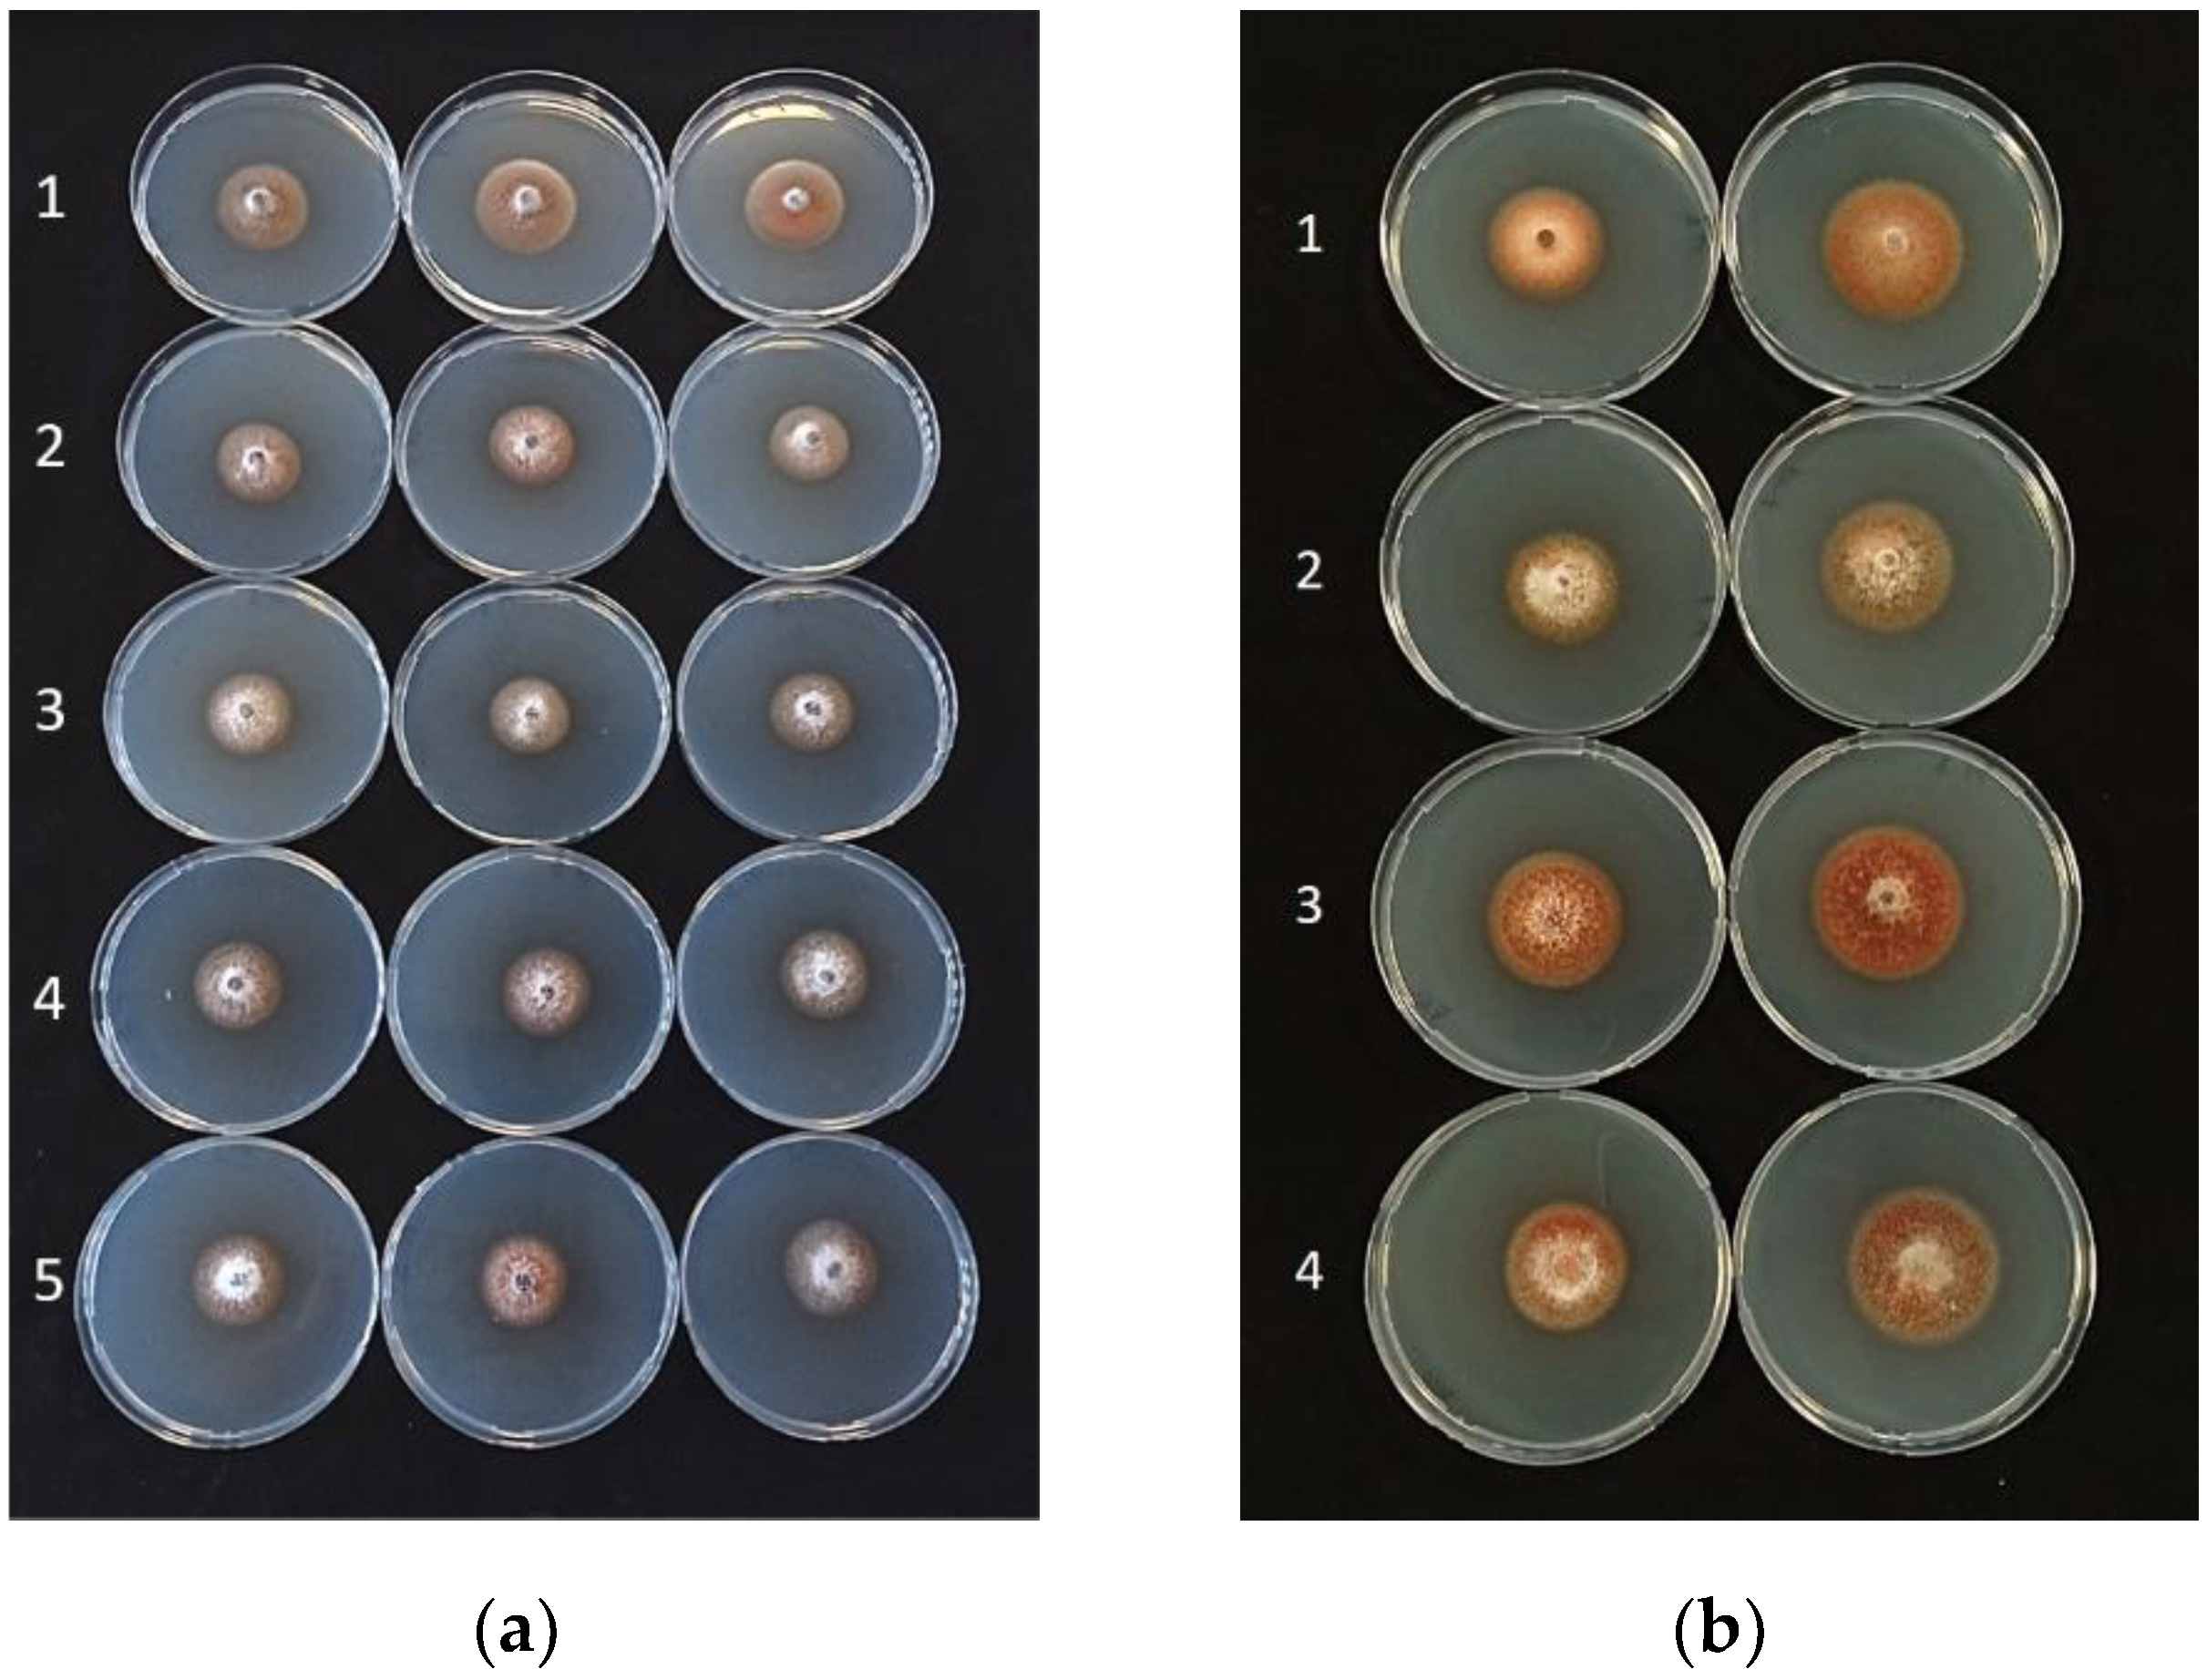
Plants 11 00446 g003
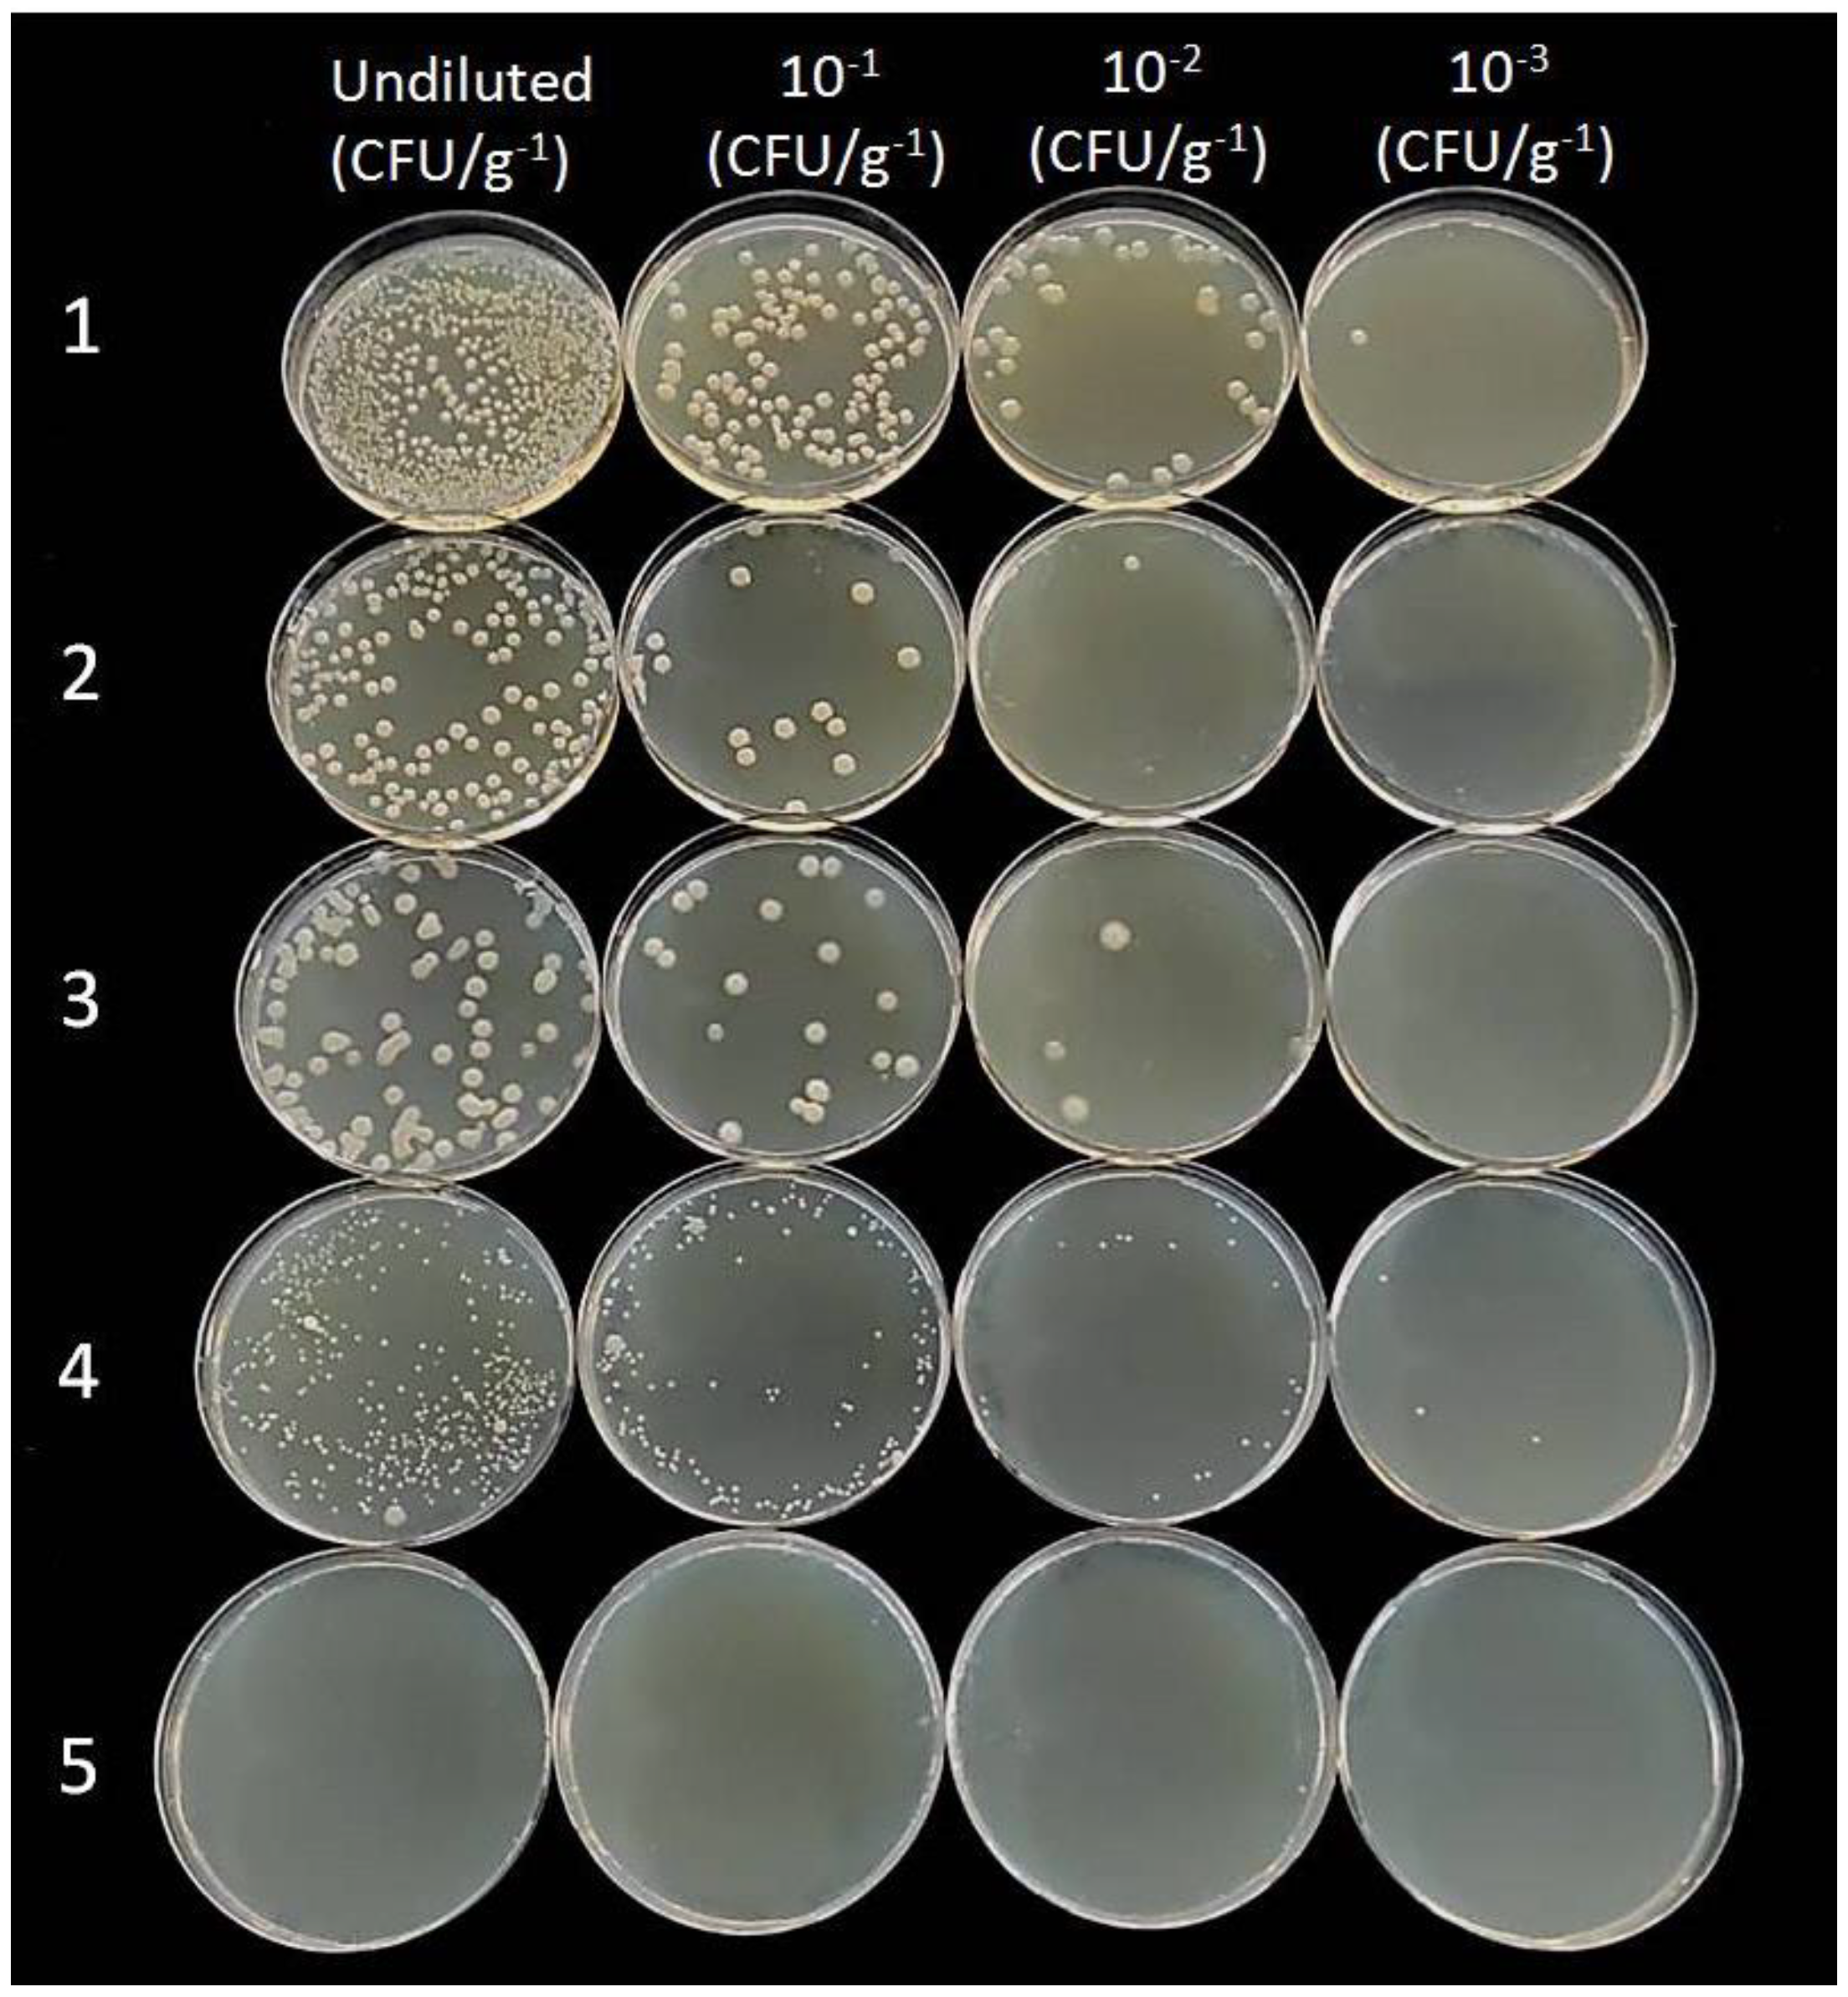
Plants 11 00446 g006

A New Strategy to Improve Management of Citrus Mal Secco Disease Using Bioformulates Based on Bacillus amyloliquefaciens Strains
Abstract
:1. Introduction
2. Results
2.1. Isolation and Characterization of P. tracheiphilus Isolates
2.2. In Vitro Activity Evaluation of BCAs against P. tracheiphilus
2.3. Virulence Assessment of P. tracheiphilus Isolates
2.4. In Planta Activity Evaluation of BCAs against P. tracheiphilus in Comparison with Standard Fungicides
2.5. Endophytic Colonization of Woody Stem by Bacillus spp.
3. Discussion
4. Materials and Methods
4.1. Isolation and Characterization of P. tracheiphilus Isolates
4.2. In Vitro Activity Evaluation of BCAs against P. tracheiphilus
4.2.1. Activity of BCA Cells
4.2.2. Activity of Cell-Free Culture Filtrates
4.2.3. Activity of Volatile Organic Compounds (VOCs)
4.3. Virulence Assessment of P. tracheiphilus Isolates
4.4. In Planta Activity Evaluation of BCAs against P. tracheiphilus
4.5. Endophytic Colonization of Woody Stem by Bacillus spp.
4.6. Data Analysis
Author Contributions
Funding
Institutional Review Board Statement
Informed Consent Statement
Data Availability Statement
Conflicts of Interest
References
- FAOSTAT. Food and Agriculture Organization of the United Nations. 2020. Available online: http://www.fao.org/faostat/en/#home (accessed on 26 December 2021).
- Bacarella, S.; Columba, P. Aspetti Commerciali ed Economici Degli Agrumi Siciliani; Dipartimento di Economia dei Sistemi Agro-Forestali: Palermo, Italy, 2002. [Google Scholar]
- Ruggieri, G. Periodicità nelle infezioni di “mal secco” e fondamentali orientamenti di lotta. Giornale di Agricoltura 1953, 34, 1–8. [Google Scholar]
- EPPO. European and Mediterranean Plant Protection Organization. 2021. Available online: https://gd.eppo.int/ (accessed on 26 December 2021).
- Nigro, F.; Ippolito, A.; Salerno, M.G. Mal secco disease of citrus: A journey through a century of research. J. Plant Pathol. 2011, 93, 523–560. [Google Scholar]
- Migheli, Q.; Cacciola, S.O.; Balmas, V.; Pane, A.; Ezra, D.; Magnano di San Lio, G. Mal secco disease caused by Phoma tracheiphila: A potential threat to lemon production worldwide. Plant Dis. 2009, 93, 852–867. [Google Scholar] [CrossRef] [Green Version]
- D.M. 17 Aprile 1998. Disposizioni Sulla Lotta Contro il Mal Secco Degli Agrumi «Phoma tracheiphila». Gazzetta Ufficiale del 2 Giugno 1998, n. 126. Available online: https://www.gazzettaufficiale.it/eli/gu/1998/06/02/126/sg/pdf (accessed on 26 December 2021).
- D.D.G. N° 2558 1 Settembre 2020. Misure Fitosanitarie Ufficiali Contro il Malsecco Degli Agrumi—Plenodomus tracheiphilus. Gazzetta Ufficiale della Regione Siciliana dell’11 Settembre 2020, n. 47. Available online: http://www.gurs.regione.sicilia.it/Gazzette/g20-47/g20-47.pdf (accessed on 26 December 2021).
- Gentile, A.; Deng, Z.; La Malfa, S.; Distefano, G.; Domina, F.; Vitale, A.; Polizzi, G.; Lorito, M.; Tribulato, E. Enhanced resistance to Phoma tracheiphila and Botrytis cinerea in transgenic lemon plants expressing a Trichoderma harzianum chitinase gene. Plant Breed. 2007, 126, 146–151. [Google Scholar] [CrossRef]
- Catalano, C.; Di Guardo, M.; Distefano, G.; Caruso, M.; Nicolosi, E.; Deng, Z.; Gentile, A.; La Malfa, S.G. Novel Approaches for Genetic Improvement of Lemon (Citrus limon (L.) Burm. f.) against Mal Secco Disease. Plants 2021, 10, 1002. [Google Scholar] [CrossRef]
- European Union. Regulation (EU) 2018/1981 of the European Parliament and of the Council of 13 December 2018 Renewing the Approval of the Active Substances Copper Compounds, as Candidates for Substitution, in Accordance with Regulation (EC) No 1107/2009 of the European Parliament and of the Council Concerning the Placing of Plant Protection Products on the Market, and Amending the Annex to Commission Implementing Regulation (EU) No 540/2011. Off. J. Eur. Union 2018. Available online: https://eur-lex.europa.eu/legal-content/EN/TXT/PDF/?uri=CELEX:32018R1981&from=EN (accessed on 26 December 2021).
- Deng, H.; Li, X.F.; Cheng, W.D.; Zhu, Y.G. Resistance and resilience of Cu-polluted soil after Cu perturbation, tested by a wide range of soil microbial parameters. FEMS Microbiol. Ecol. 2009, 70, 137–148. [Google Scholar] [CrossRef] [Green Version]
- Hippler, F.W.R.; Petená, G.; Boaretto, R.M.; Quaggio, J.A.; Azevedo, R.A.; Mattos, D. Mechanisms of copper stress alleviation in Citrus trees after metal uptake by leaves or roots. Environ. Sci. Pollut. Res. 2018, 25, 13134–13146. [Google Scholar] [CrossRef]
- Aiello, D.; Ferrante, P.; Vitale, A.; Polizzi, G.; Scortichini, M.; Cirvilleri, G. Characterization of Pseudomonas syringae pv. syringae isolated from mango in Sicily and occurrence of copper-resistant strains. J. Plant. Pathol. 2015, 97, 273–282. [Google Scholar]
- Behlau, F.; Canteros, B.I.; Jones, J.B.; Graham, H.J. Copper resistance genes from different xanthomonads and citrus epiphytic bacteria confer resistance to Xanthomonas citri subsp. citri. Eur. J. Plant Pathol. 2012, 133, 949–963. [Google Scholar] [CrossRef]
- Kandeler, E.; Kampichler, C.; Horak, O. Influence of heavy metals on the functional diversity of soil communities. Biol. Fertil. Soils 1996, 23, 299–306. [Google Scholar] [CrossRef]
- Solomon, F. Impacts of copper on aquatic ecosystems and human health. Environ. Commun. 2009, 25–28. [Google Scholar]
- Buckwell, A.; De Wachter, E.; Nadeu, E.; Williams, A. Crop Protection & the EU Food System. Where Are They Going? RISE Foundation: Brussel, Belgium, 2020. [Google Scholar]
- Katsoulas, N.; Loes, A.K.; Andrivon, D.; Cirvilleri, G.; de Cara, M.; Kir, A.; Knebl, L.; Malinska, K.; Oudshoorn, F.W.; Willer, H.; et al. Current use of copper, mineral oils and sulphur for plant protection in organic horticultural crops across 10 European countries. Org. Agric. 2020, 10, 159–171. [Google Scholar] [CrossRef]
- Lima, G.; Ippolito, A.; Nigro, F.; Salerno, M. Tentativi di lotta biologica contro il mal secco degli agrumi (Phoma tracheiphila) a mezzo di batteri endofiti. La Difesa delle Piante 1994, 17, 43–49. [Google Scholar]
- Kalai-Grami, L.; Ben Slimane, I.; Mnari-Hattab, M.; Rezgui, S.; Aouani, M.A.; Hajlaoui, M.R.; Limam, F. Protective effect of Bacillus amyloliquefaciens against infections of Citrus aurantium seedlings by Phoma tracheiphila. World J. Microbiol. Biotechnol. 2013, 30, 529–538. [Google Scholar] [CrossRef]
- Ngalimat, M.S.; Yahaya, R.S.R.; Baharudin, M.M.A.-a.; Yaminudin, S.M.; Karim, M.; Ahmad, S.A.; Sabri, S. A Review on the Biotechnological Applications of the Operational Group Bacillus amyloliquefaciens. Microorganisms 2021, 9, 614. [Google Scholar] [CrossRef]
- Chen, K.; Tian, Z.; He, H.; Long, C.; Jiang, F. Bacillus species as potential biocontrol agents against citrus diseases. Biol. Control 2020, 151, 104419. [Google Scholar] [CrossRef]
- Fira, D.; Dimkić, I.; Berić, T.; Lozo, J.; Stanković, S. Biological control of plant pathogens by Bacillus species. J. Biotechnol. 2018, 285, 44–55. [Google Scholar] [CrossRef]
- Yánez-Mendizábal, V.; Usall, J.; Viñas, I.; Casals, C.; Marín, S.; Solsona, C.; Teixidó, N. Potential of a new strain of Bacillus subtilis CPA-8 to control the major postharvest diseases of fruit. Biocontrol Sci. Technol. 2011, 21, 409–426. [Google Scholar] [CrossRef]
- Singh, V.; Deverall, B. Bacillus subtilis as a control agent against fungal pathogens of citrus fruit. Transact. Br. Mycol. Soc. 1984, 83, 487–490. [Google Scholar] [CrossRef]
- Ongena, M.; Jacques, P. Bacillus lipopeptides: Versatile weapons for plant disease biocontrol. Trends Microbiol. 2008, 16, 115–125. [Google Scholar] [CrossRef]
- Aiello, D.; Guarnaccia, V.; Azzaro, A.; Polizzi, G. Alternaria brown spot on new clones of sweet orange and lemon in Italy. Phytopathol. Mediterr. 2020, 59, 131–145. [Google Scholar]
- Vitale, A.; Aiello, D.; Azzaro, A.; Guarnaccia, V.; Polizzi, G. An Eleven-Year Survey on Field Disease Susceptibility of Citrus Accessions to Colletotrichum and Alternaria Species. Agriculture 2021, 11, 536. [Google Scholar] [CrossRef]
- Piccirillo, G.; Carrieri, R.; Polizzi, G.; Azzaro, A.; Lahoz, E.; Fernández-Ortuño, D.; Vitale, A. In vitro and in vivo activity of QoI fungicides against Colletotrichum gloeosporioides causing fruit anthracnose in Citrus sinensis. Sci. Hortic. 2018, 236, 90–95. [Google Scholar] [CrossRef]
- Borriss, R. Phytostimulation and biocontrol by the plant-associated Bacillus amyloliquefaciens FZB42: An update. In Bacilli and Agrobiotechnology; Islam, M.T., Rahman, M., Pandey, P., Jha, C.K., Eds.; Springer International Publishing AG: Berlin, Germany, 2016; pp. 163–184. [Google Scholar]
- Aiello, D.; Restuccia, C.; Stefani, E.; Vitale, A.; Cirvilleri, G. Postharvest biocontrol ability of Pseudomonas synxantha against Monilinia fructicola and Monilinia fructigena on stone fruit. Postharvest Biol. Technol. 2019, 149, 83–89. [Google Scholar] [CrossRef]
- Luisi, N.; De Cicco, V.; Cutuli, G.; Salerno, M. Analisi della patogenicità di Phoma tracheiphila (Petri) Kanc. et Ghik. su alcune specie e cultivar di Agrumi. Phytopathol. Mediterr. 1979, 18, 162–165. [Google Scholar]
- Araújo, W.L.; Marcon, J.; Maccheroni, W.J.; van Elsas, J.D.; van Vuurde, J.W.L.; Azevedo, J.L. Diversity of endophytic bacterial populations and their interaction with Xylella fastidiosa in citrus plants. Appl. Environ. Microbiol. 2002, 68, 4906–4914. [Google Scholar] [CrossRef] [Green Version]

| Treatment | Average Mycelial Growth (cm) of Plenodomus tracheiphilus Isolates (PT) 1 | |||||||
|---|---|---|---|---|---|---|---|---|
| PT1 | PT3 | PT4 | PT5 | PT6 | PT7 | PT8 | PT9 | |
| Control | 3.27 ± 0.01 a | 2.68 ± 0.06 a | 2.73 ± 0.04 a | 3.37± 0.01 a | 2.95 ± 0.07 a | 2.73 ± 0.11 a | 3.17 ± 0.05 a | 3.38 ± 0.15 a |
| B. amyloliquefaciens D747 (Amylo-X®) | 1.03 ± 0.03 b | 1.05 ± 0.03 b | 0.95 ± 0.03 b | 1.07 ± 0.06 b | 0.90 ± 0.05 b | 0.65 ± 0.12 b | 0.92 ± 0.05 b | 1.00 ± 0.11 b |
| B. amyloliquefaciens FZB24 (Taegro®) | 0.48 ± 0.08 c | 0.78 ± 0.05 c | 0.63 ± 0.03 c | 0.40 ± 0.04 c | 0.42 ± 0.13 c | 0.45 ± 0.07 bc | 0.50 ± 0.00 c | 0.42 ± 0.04 c |
| B. amyloliquefaciens MBI600 (Serifel®) | 0.52 ± 0.05 c | 0.62 ± 0.08 c | 0.53 ± 0.04 c | 0.48 ± 0.06 c | 0.30 ± 0.05 cd | 0.43 ± 0.03 bc | 0.28 ± 0.01 d | 0.37 ± 0.03 c |
| B. amyloliquefaciens QST713 (former B. subtilis; Serenade®Aso) | 0.23 ± 0.03 d | 0.38 ± 0.04 d | 0.18 ± 0.08 d | 0.20 ± 0.00 d | 0.10 ± 0.05 d | 0.18 ± 0.08 c | 0.20 ± 0.00 d | 0.33 ± 0.08 c |
| Treatment | Average Mycelial Growth (cm) of Plenodomus tracheiphilus Isolates 1 | |||||||
|---|---|---|---|---|---|---|---|---|
| PT1 | PT3 | PT4 | PT5 | PT6 | PT7 | PT8 | PT9 | |
| Control | 2.48 ± 0.01 a | 2.57 ± 0.04 a | 2.68 ± 0.08 a | 2.48 ± 0.06 a | 2.77 ± 0.23 a | 2.58 ± 0.07 a | 3.25 ± 0.04 a | 2.60 ± 0.05 a |
| B. amyloliquefaciens D747 (Amylo-X®) | 2.27 ± 0.03 b | 2.33 ± 0.03 b | 2.25 ± 0.07 b | 1.87 ± 0.11 b | 2.50 ± 0.03 abc | 1.70 ± 0.16 c | 2.45 ± 0.03 bc | 2.20 ± 0.07 b |
| B. amyloliquefaciens FZB24 (Taegro®) | 2.27 ± 0.08 b | 2.23 ± 0.06 bc | 2.20 ± 0.10 b | 1.98 ± 0.01 b | 2.73 ± 0.03 ab | 2.25 ± 0.07 ab | 2.58 ± 0.04 b | 2.07 ± 0.12 b |
| B. amyloliquefaciens MBI600 (Serifel®) | 1.97 ± 0.01 c | 2.13 ± 0.10 cd | 1.47 ± 0.01 c | 1.55 ± 0.00 c | 2.35 ± 0.08 bc | 1.58 ± 0.21 c | 2.47 ± 0.18 bc | 1.72 ± 0.01 c |
| B. amyloliquefaciens QST713 (former B. subtilis; Serenade®Aso) | 1.87 ± 0.07 c | 1.98 ± 0.01 d | 1.68 ± 0.10 c | 1.62 ± 0.03 c | 2.23 ± 0.01 c | 1.87 ± 0.18 bc | 2.02 ± 0.26 c | 1.63 ± 0.04 c |
| Treatment | Average Mycelial Growth (cm) of Plenodomus tracheiphilus Isolates 1 | |||||||
|---|---|---|---|---|---|---|---|---|
| PT1 | PT3 | PT4 | PT5 | PT6 | PT7 | PT8 | PT9 | |
| Control | 3.22 ± 0.11 a | 2.97 ± 0.02 a | 3.20 ± 0.00 a | 3.18 ± 0.06 a | 3.33 ± 0.04 a | 3.02 ± 0.06 a | 3.37 ± 0.03 a | 3.28 ± 0.03 a |
| B. amyloliquefaciens D747 (Amylo-X®) | 2.78 ± 0.04 b | 2.80 ± 0.03 b | 2.67 ± 0.04 b | 2.58 ± 0.04 b | 2.33 ± 0.07 c | 2.30 ± 0.06 b | 2.57 ± 0.09 c | 2.68 ± 0.06 b |
| B. amyloliquefaciens FZB24 (Taegro®) | 2.70 ± 0.08 bc | 2.65 ± 0.03 c | 2.50 ± 0.05 b | 2.72 ± 0.02 b | 2.45 ± 0.08 bc | 2.32 ± 0.12 b | 2.47 ± 0.09 c | 2.43 ± 0.07 c |
| B. amyloliquefaciens MBI600 (Serifel®) | 2.42 ± 0.20 c | 2.67 ± 0.03 c | 2.50 ± 0.1 b | 2.62 ± 0.06 b | 2.62 ± 0.04 b | 2.52 ± 0.04 b | 2.92 ± 0.13 b | 2.65 ± 0.08 b |
| B. amyloliquefaciens QST713 (former B. subtilis; Serenade®Aso) | 2.37 ± 0.07 c | 2.78 ± 0.04 b | 2.60 ± 0.15 b | 2.68 ± 0.03 b | 2.52 ± 0.04 b | 2.52 ± 0.21 b | 2.60 ± 0.08 c | 2.57 ± 0.03 bc |
| P. tracheiphilus Isolates | DI (%) 10 dai 1 | SS 10 dai 1 | DI (%) 20 dai 1 | SS 20 dai 1 | DI (%) 30 dai 1 | SS 30 dai 1 |
|---|---|---|---|---|---|---|
| PT1 | 37.0 ± 6.7 d | 0.8 ± 0.1 c | 46.3 ± 5.0 cd | 1.1 ± 0.2 b | 48.0 ± 4.0 cd | 1.4 ± 0.2 c |
| PT3 | 42.7 ± 10.5 cd | 1.0 ± 0.3 bc | 42.7 ± 10.5 d | 1.2 ± 0.4 b | 42.7 ± 10.5 d | 1.4 ± 0.3 c |
| PT4 | 46.3 ± 3.7 bcd | 1.2 ± 0.2 abc | 52.0 ± 4.0 bcd | 1.6 ± 0.2 ab | 54.0 ± 2.0 bcd | 2.2 ± 0.3 bc |
| PT5 | 48.0 ± 6.7 bcd | 1.3 ± 0.1 abc | 66.7 ± 3.2 ab | 2.4 ± 0.1 a | 72.3 ± 3.2 ab | 2.8 ± 0.1 ab |
| PT6 | 57.3 ± 6.9 abcd | 1.5 ± 0.1 ab | 68.3 ± 3.7 ab | 2.1 ± 0.1 a | 68.3 ± 3.7 abc | 2.5 ± 0.2 ab |
| PT7 | 65.0 ± 6.7 ab | 1.2 ± 0.2 abc | 68.7 ± 9.3 ab | 2.3 ± 0.5 a | 66.7 ± 11.3 abc | 2.4 ± 0.5 ab |
| PT8 | 63.3 ± 3.7 abc | 1.6 ± 0.3 ab | 65.0 ± 4.7 abc | 1.8 ± 0.3 ab | 68.7 ± 7.8 abc | 2.7 ± 0.3 ab |
| PT9 | 72.33 ± 8.3 a | 1.74 ± 0.1 a | 79.7 ± 5.0 a | 2.3 ± 0.1 a | 83.3 ± 5.7 a | 3.1 ± 0.3 a |
| Factor(s) | df | Parameters 1 | |||||||
|---|---|---|---|---|---|---|---|---|---|
| DI (%) 20 dai | SS (1-to-5) 20 dai | DI (%) 30 dai | SS (1-to-5) 30 dai | ||||||
| F | p Value | F | p Value | F | p Value | F | p Value | ||
| Treatment | 7 | 94.424 | 0.000003 | 35.322 | 0.006373 | 12.356 | 0.000000 | 84.939 | 0.000007 |
| Treatment × trial | 7 | 14.588 | 0.2172 ns | 0.8841 | 0.5300 ns | 0.8650 | 0.5440 ns | 0.9814 | 0.4617 ns |
| Treatment | DI (%) 20 dai 1 | SS 20 dai 1 | DI (%) 30 dai 1 | SS 30 dai 1 |
|---|---|---|---|---|
| Control | 39.17 ± 0.50 a | 0.72 ± 0.08 a | 43.33 ± 5.66 a | 1.07 ± 0.19 a |
| B. amyloliquefaciens D747(Amylo-X®) | 28.33 ± 7.33 b | 0.55 ± 0.32 ab | 30.50 ± 12.96 b | 0.73 ± 0.57 b |
| B. amyloliquefaciens MBI600 (Serifel®) | 25.00 ± 6.63 b | 0.43 ± 0.17 bc | 27.83 ± 12.02 b | 0.63 ± 0.38 bc |
| B. amyloliquefaciens FZB24 (Taegro®) | 24.50 ± 8.83 b | 0.45 ± 0.18 bc | 28.17 ± 16.26 b | 0.63 ± 0.33 bc |
| B. amyloliquefaciens QST713 (former B. subtilis; Serenade®Aso) | 23.00 ± 6.67 bc | 0.40 ± 0.20 bc | 26.17 ± 12.02 bc | 0.58 ± 0.40 bc |
| Copper hydroxide (Kocide 2000®) | 16.00 ± 2.67 cd | 0.30 ± 0.17 c | 18.83 ± 7.31 cd | 0.42 ± 0.31 cd |
| Fludioxonil (Geoxe®) | 15.33 ± 9.00 d | 0.33 ± 0.23 c | 16.17 ± 13.44 d | 0.38 ± 0.40 d |
| Mancozeb (Penncozeb® DG) | 14.67 ± 9.67 d | 0.30 ± 0.27 c | 15.00 ± 13.20 d | 0.38 ± 0.45 d |
| Active Ingredient | Trade Name | Manufacturer | Rates (g or mL/100 L) | Formulation 1 |
|---|---|---|---|---|
| Bacillus amyloliquefaciens strain QST713 (former B. subtilis) | Serenade®Aso Aso | Bayer Crop Science S.r.l., Milano, Italy | 600 | 1.34 SC |
| Bacillus amyloliquefaciens subsp. plantarum strain D747 | Amylo-X® | Biogard, Brussels, Belgium | 350 | 5 LC |
| Bacillus amyloliquefaciens strain FZB24 | Taegro® | Syngenta, Bagsvaerd, Denmark | 25 | 13 WP |
| Bacillus amyloliquefaciens strain MBI600 | Serifel® | BASF S.p.A. Italia, Cesano Maderno, Italia | 50 | 8.8 WP |
| Copper hydroxide | Kocide 2000® | Certis Europe B.V., Saronno (VA), Italy | 150 | 35 WG |
| Mancozeb | Penncozeb® DG | UPL Italia S.r.l., S. Carlo di Cesena (FC) Italy | 300 | 75 WG |
| Fludioxonil | Geoxe® | Syngenta Italia S.p.A., Milano, Italy | 40 | 50 WG |
Publisher’s Note: MDPI stays neutral with regard to jurisdictional claims in published maps and institutional affiliations. |
© 2022 by the authors. Licensee MDPI, Basel, Switzerland. This article is an open access article distributed under the terms and conditions of the Creative Commons Attribution (CC BY) license (https://creativecommons.org/licenses/by/4.0/).
Share and Cite
Aiello, D.; Leonardi, G.R.; Di Pietro, C.; Vitale, A.; Polizzi, G. A New Strategy to Improve Management of Citrus Mal Secco Disease Using Bioformulates Based on Bacillus amyloliquefaciens Strains. Plants 2022, 11, 446. https://doi.org/10.3390/plants11030446
Aiello D, Leonardi GR, Di Pietro C, Vitale A, Polizzi G. A New Strategy to Improve Management of Citrus Mal Secco Disease Using Bioformulates Based on Bacillus amyloliquefaciens Strains. Plants. 2022; 11(3):446. https://doi.org/10.3390/plants11030446
Chicago/Turabian StyleAiello, Dalia, Giuseppa Rosaria Leonardi, Chiara Di Pietro, Alessandro Vitale, and Giancarlo Polizzi. 2022. "A New Strategy to Improve Management of Citrus Mal Secco Disease Using Bioformulates Based on Bacillus amyloliquefaciens Strains" Plants 11, no. 3: 446. https://doi.org/10.3390/plants11030446
APA StyleAiello, D., Leonardi, G. R., Di Pietro, C., Vitale, A., & Polizzi, G. (2022). A New Strategy to Improve Management of Citrus Mal Secco Disease Using Bioformulates Based on Bacillus amyloliquefaciens Strains. Plants, 11(3), 446. https://doi.org/10.3390/plants11030446







